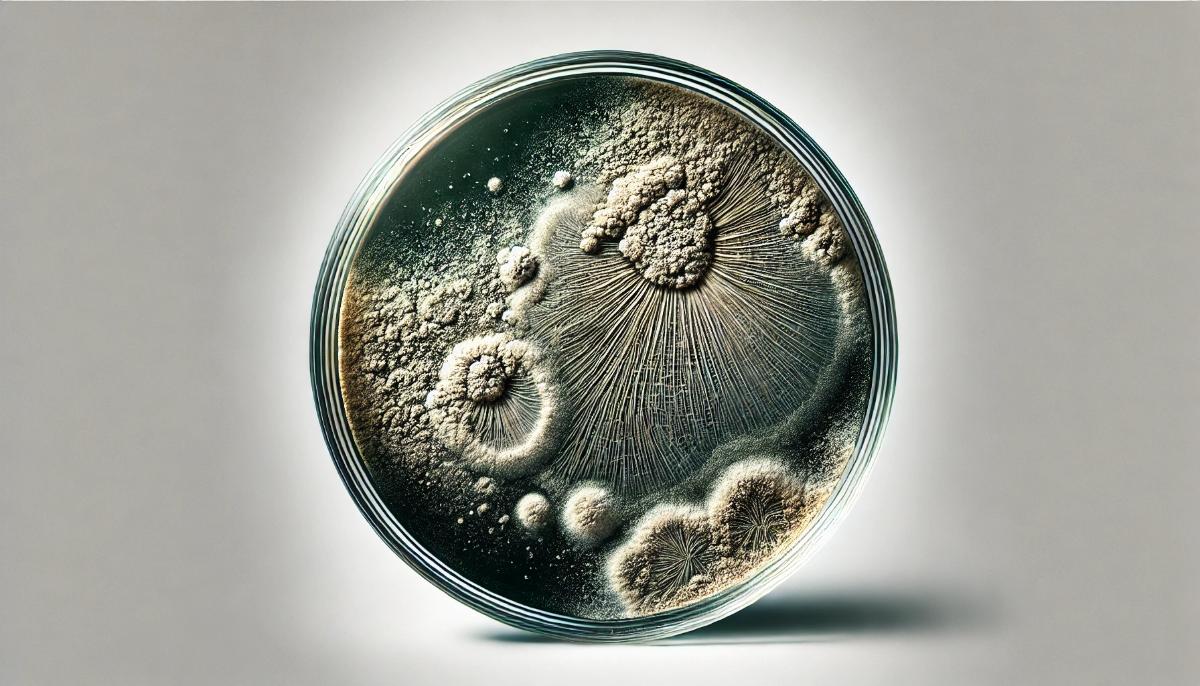
qfmakallpjpwl7kl2x01cfr47ebgjvuw.jpg

От случайной плесени к спасению миллионов: медальон Флеминга продан за $76 000
NewsMakerСекреты прошлого всё еще удивляют и дорого стоят.

Редкий образец плесени, который послужил основой для открытия пенициллина Александром Флемингом, был продан на аукционе за рекордные 76 тысяч долларов. Прогнозируемая стоимость лота ранее оценивалась примерно в 50 тысяч долларов, но на торгах, проведенных 23 октября аукционным домом Bonham's в рамках распродажи «История науки и технологий», уникальный экспонат, известный как «медальон с плесенью», установил мировой рекорд.
История открытия пенициллина связана с удивительным совпадением, которое изменило будущее медицины. Во время одного из отпусков Флеминг оставил несколько чашек Петри с бактериями стафилококка. По возвращении он заметил, что в одной из чашек появилась плесень, вокруг которой отсутствовал рост бактерий. Исследователь предположил, что плесень выделяет химическое вещество, предотвращающее развитие бактерий, и назвал его пенициллином.
Работы Флеминга привели к созданию антибиотиков, которые до сих пор спасают жизни, предотвращая смертельные инфекции. Несколько образцов плесени, произведенной в ходе его экспериментов, были сохранены до наших дней, но на последнем аукционе этот экземпляр достиг наивысшей стоимости — 76 тысяч долларов.
Старший специалист отдела редких книг и рукописей аукционного дома Bonham’s, Даррен Сазерленд, отметил важность открытия, которое радикально изменило ход истории, впервые дав медицине возможность бороться с многочисленными заболеваниями и инфекциями. По его словам, данный экземпляр плесени Флеминга привлек значительный интерес коллекционеров по всему миру, что и позволило установить мировой рекорд на этот редкий научный артефакт.
Этот год отмечен серией рекордных аукционных продаж научных реликвий. В июле за 44,6 миллиона долларов был продан скелет стегозавра по имени А́пекс, побивший предыдущий рекорд стоимости окаменелостей, установленный тираннозавром Стэном, на 10 миллионов долларов.
Однако высокие цены на такие экспонаты вызывают споры. Некоторые специалисты считают, что реликвии науки должны оставаться доступными для академического сообщества, а не переходить в частные коллекции. В свете быстро растущей стоимости палеонтологических находок этот аргумент приобретает всё большую актуальность.
Редкий образец плесени, который послужил основой для открытия пенициллина Александром Флемингом, был продан на аукционе за рекордные 76 тысяч долларов. Прогнозируемая стоимость лота ранее оценивалась примерно в 50 тысяч долларов, но на торгах, проведенных 23 октября аукционным домом Bonham's в рамках распродажи «История науки и технологий», уникальный экспонат, известный как «медальон с плесенью», установил мировой рекорд.
История открытия пенициллина связана с удивительным совпадением, которое изменило будущее медицины. Во время одного из отпусков Флеминг оставил несколько чашек Петри с бактериями стафилококка. По возвращении он заметил, что в одной из чашек появилась плесень, вокруг которой отсутствовал рост бактерий. Исследователь предположил, что плесень выделяет химическое вещество, предотвращающее развитие бактерий, и назвал его пенициллином.
Работы Флеминга привели к созданию антибиотиков, которые до сих пор спасают жизни, предотвращая смертельные инфекции. Несколько образцов плесени, произведенной в ходе его экспериментов, были сохранены до наших дней, но на последнем аукционе этот экземпляр достиг наивысшей стоимости — 76 тысяч долларов.
Старший специалист отдела редких книг и рукописей аукционного дома Bonham’s, Даррен Сазерленд, отметил важность открытия, которое радикально изменило ход истории, впервые дав медицине возможность бороться с многочисленными заболеваниями и инфекциями. По его словам, данный экземпляр плесени Флеминга привлек значительный интерес коллекционеров по всему миру, что и позволило установить мировой рекорд на этот редкий научный артефакт.
Этот год отмечен серией рекордных аукционных продаж научных реликвий. В июле за 44,6 миллиона долларов был продан скелет стегозавра по имени А́пекс, побивший предыдущий рекорд стоимости окаменелостей, установленный тираннозавром Стэном, на 10 миллионов долларов.
Однако высокие цены на такие экспонаты вызывают споры. Некоторые специалисты считают, что реликвии науки должны оставаться доступными для академического сообщества, а не переходить в частные коллекции. В свете быстро растущей стоимости палеонтологических находок этот аргумент приобретает всё большую актуальность.